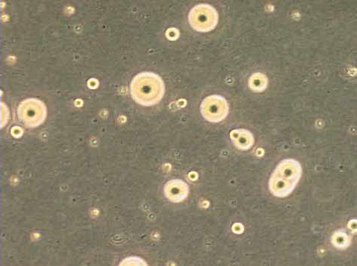
Detection of mycoplasma

Testing Cells for Mycoplasma Contamination by Culture Isolation
Aim

Figure 1.Testing Cells for Mycoplasma Contamination
Detection of mycoplasma by culture isolation methods is the reference method of detection and has a theoretical level of detection of 1 colony-forming unit (cfu). However, there are some strains of mycoplasma that are non-cultivable (certain strains of Mycoplasma hyorhinis). The method is suitable for the detection of mycoplasma in both cell cultures and cell culture reagents and results are obtained within 4 weeks. Mycoplasma colonies observed on agar plates have a ‘fried egg’ appearance.
Materials
- 70% (v/v) alcohol in sterile water (793213)
- Mycoplasma plates
- Mycoplasma horse serum broths (M0535)
- M. orale (NCTC* 10112)
- M. pneumoniae (NCTC* 10119)
* Available from the National Collection of Type Cultures (NCTC)
Equipment
- Personal protective equipment (sterile gloves, laboratory coat, safety visor)
- Waterbath set to 37 °C
- Microbiological safety cabinet at appropriate containment level
- Incubator set at 36 °C
- Anaerobic jar system
Procedure
- Inoculate 2 agar plates with 0.2mL of test sample.
- Inoculate 2 plates with 100 cfu of each control organism.
- Leave 2 plates un-inoculated as a negative control.
- Inoculate 1 broth with 10mL of test sample.
- Inoculate a broth with 100 cfu of each control organism.
- Leave 1 broth un-inoculated as a negative control.
- Incubate agar plates anaerobically for 14 days at 36 °C.
- Incubate broths aerobically for 14 days at 36 °C.
- Between days 3 - 7 and 10 - 14 of incubation, subculture 0.1 mL of test broth onto an agar plate and incubate plate anaerobically as above.
- Observe agar plates after 14 days incubation at x4 magnification using an inverted microscope for the presence of mycoplasma colonies (Figure 9).
Criteria for a Valid Result
All positive control agar plates and broths show evidence of mycoplasma by typical colony formation on agar plates and usually a color change in broths. All negative control agar plates and broths show no evidence of mycoplasma.
Criteria for a Positive Result
Test agar plates infected with mycoplasma show typical colony formation.
Criteria for a Negative Result
The test agar plates show no evidence of mycoplasma.
Notes
Figure 2.Detection of mycoplasma
- Mycoplasma colonies have a typical colony formation commonly described as “fried egg” to the opaque granular central zone of growth penetrating the agar surrounded by a flat translucent peripheral zone on the surface.
- Mycoplasma pneumoniae is a potential pathogen and must be handled in a class 2 microbiological safety cabinet operating to ACDP Category 2 Conditions.
- This test procedure should be carried out in a microbiology laboratory away from the cell culture laboratory.
- ECACC recommends that samples are tested for mycoplasma using at least two detection methods (e.g. indirect DNA stain and culture isolation) for a more reliable result. This is due to the varying detection sensitivities of the methods for different species of mycoplasma.
- ECACC also offers a mycoplasma screening PCR assay which can return a result within 24 hours.
To continue reading please sign in or create an account.
Don't Have An Account?